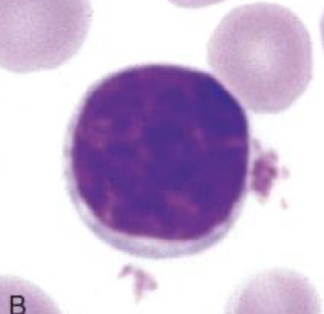
<p><span>Which type of white blood cell is shown in this picture? What are the characteristics of this type of white blood cell?</span></p>

Lecture 3 -- Leucocyte and Platelet Abnormalities
1/26
Earn XP
Description and Tags
These flashcards cover key concepts about leucocyte and platelet abnormalities as discussed in the lecture.
Name | Mastery | Learn | Test | Matching | Spaced | Call with Kai |
|---|
No analytics yet
Send a link to your students to track their progress
27 Terms

Which type of white blood cell is shown in this picture? What are the characteristics of this type of white blood cell?
Eosinophil
Eosinophilia (Organ-pink granules) in cytoplasm
Segmented nucleus

Which type of white blood cell is shown in this picture? What are the characteristics of this type of white blood cell?
Neutrophil
Segmented nucleus
Clear cytoplasm

What indicates a left shift in neutrophils?
Monocyte
Vacuoles can be observed in cytoplasm
Grey cytoplasm
Biggest among all WBCs
Various shape of nucleus

Which type of white blood cell is shown in this picture? What are the characteristics of this type of white blood cell?
Basophil
Looks similar to eosinophils
Segmented nucleus
BUT basophilia = Purple cytoplasm
Which type of white blood cell is shown in this picture? What are the characteristics of this type of white blood cell?
Lymphocyte
Large, round nucleus
Thin rim of cytoplasm
Similar size or slightly bigger than erythrocytes
What may be misclassified as lymphocytes by a haematology analyser, causing a false increase in WBC count?
Nucleated red blood cells
When interpreting leukocytes, which is more useful: total WBC count or differential WBC count?
Differential WBC count
What does a differential WBC count measure?
The percentages of different types of leucocytes in the blood.
How can you calculate the absolute number of a specific leucocyte type?
Multiply the percentage of the leucocyte type by the total WBC count.
What does the term 'toxic changes' refer to in neutrophils?
Morphological alterations indicating inflammation
What toxic changes can be observed in neutrophils?
Foamy cytoplasm → Vacuoles in cytoplasm
Diffuse cytoplasmic basophilia → Blue/purple cytoplasm instead of clear
Döhle bodies → Blue granules in cytoplasm

Which type of white blood cell is shown in this picture? What are the characteristics of this type of white blood cell?
Reactive lymphocytes
Larger than normal lymphocytes
Eccentric nucleus(shifted to one side)
Deeply basophilic (blue) cytoplasm
What are the possible causes of neutrophilia?
Inflammation
Excess catecholamines
Fear, excitement, exercise
Excess glucocorticoids
Hyperadrenocorticism
Steroid administration
Chronic myeloid leukaemia
What are the causes of neutropenia?
Increased use:
Severe/overwhelming acute inflammation
Decreased production:
Bone marrow disorders
Myelofibrosis / myelophthisis
Toxic insult e.g. chemotherapy
Infections (e.g. FeLV, parvovirus)
What leukocyte changes occur with excess catecholamines?
Neutrophilia
Lymphocytosis
Monocytosis
What leukocyte changes occur with excess glucocorticoids?
Neutrophilia
Monocytosis
Lymphopenia
Eosinopenia
What are the causes of lymphocytosis?
Chronic inflammation
Excess catecholamines
Hypoadrenocorticism
Since hyperadrenocorticism causes lymphopenia
Lymphoproliferative disease
Young animals
What are the causes of lymphopenia?
Acute inflammation/stress
Excess glucocorticoids
Hyperadrenocorticism
Lymphoma
Loss of lymphocyte-rich fluid (e.g. chylothorax drainage)
What are the causes of monocytosis?
Acute or chronic inflammation
Excess glucocorticoids
Hyperadrenocorticism
Secondary to neutropenia
What are the causes of eosinophilia?
Allergic reactions
Parasitic infections
Eosinophilic inflammatory diseases
Eosinophilic bronchopneumonia, Eosinophilic enteritis
Hypoadrenocorticism
Since hyperadrenocorticism causes eosinopenia
What are the causes of basophilia?
Parasitic infections
Hypersensitivity reactions
Neoplasia
What should you check on a haematology analyser if thrombocytopenia is reported?
Platelet clumping
Can cause false low platelet count
Which breeds may normally show thrombocytopenia?
Sighthounds
Cavalier King Charles Spaniels
What are the causes of thrombocytopenia?
Redistribution: splenomegaly
Increased consumption: DIC
Increased destruction: autoimmune disease, neoplasia
Decreased production: myelophthisis
What are the clinical signs of thrombocytopenia?
Haematuria
Epistaxis
Melaena (Digested blood in faeces)
Petechiae
Haematochezia (Blood in faeces)
What does the presence of large platelets in a thrombocytopenic animal indicate?
Active thrombopoiesis (bone marrow response)
Interpretation:
Bone marrow is functioning → production is intact
Likely causes:
Increased destruction (e.g. immune-mediated)
Increased consumption (e.g. DIC)
Less likely: decreased production
What are the causes of thrombocytosis?
Splenic contraction
Post-splenectomy
Iron deficiency anaemia
Inflammation